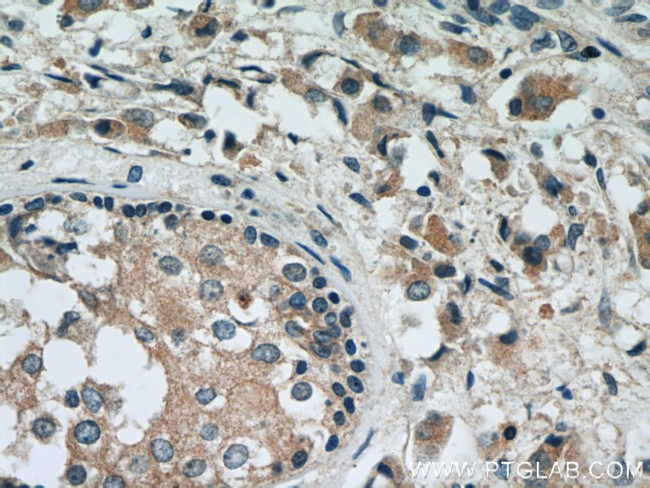
RAB2 Antibody in Immunohistochemistry (Paraffin) (IHC (P))

Search
Proteintech
RAB2 Polyclonal Antibody
{{$productOrderCtrl.translations['antibody.pdp.commerceCard.promotion.promotions']}}
{{$productOrderCtrl.translations['antibody.pdp.commerceCard.promotion.viewpromo']}}
{{$productOrderCtrl.translations['antibody.pdp.commerceCard.promotion.promocode']}}: {{promo.promoCode}} {{promo.promoTitle}} {{promo.promoDescription}}. {{$productOrderCtrl.translations['antibody.pdp.commerceCard.promotion.learnmore']}}
产品信息
15420-1-AP
种属反应
已发表种属
宿主/亚型
分类
类型
抗原
偶联物
形式
浓度
规格
纯化类型
保存液
内含物
保存条件
运输条件
产品详细信息
This antibody can recognize both RAB2A and RAB2B.
Immunogen sequence: MAYAYLFKY IIIGDTGVGK SCLLLQFTDK RFQPVHDLTI GVEFGARMIT IDGKQIKLQI WDTAGQESFR SITRSYYRGA AGALLVYDIT RRDTFNHLTT WLEDARQHSN SNMVIMLIGN KSDLESRREV KKEEGEAFAR EHGLIFMETS AKTASNVEEA FINTAKEIYE KIQEGVFDIN NEANGIKIGP QHAATNATHA GNQGGQQAGG GCC (1-212 aa encoded by BC008929)
靶标信息
Members of the Rab protein family are nontransforming monomeric GTP-binding proteins of the Ras superfamily that contain 4 highly conserved regions involved in GTP binding and hydrolysis. Rabs are prenylated, membrane-bound proteins involved in vesicular fusion and trafficking. The mammalian RAB proteins show striking similarities to the S. cerevisiae YPT1 and SEC4 proteins, Ras-related GTP-binding proteins involved in the regulation of secretion.
仅用于科研。不用于诊断过程。未经明确授权不得转售。
生物信息学
蛋白别名: GTP-binding protein; GTP-binding protein RAB2B; rab 2; RAB2, member RAS oncogene family; RAB2B; RAS family, member RAB2B; Ras-related protein Rab-2A; Ras-related protein Rab-2B; similar to human rab2 encoded by GenBank Accession Number X12953; small GTP binding protein RAB2A; unnamed protein product
基因别名: 1500012D09Rik; 4930528G15Rik; 9330148M11Rik; A230002G14; C80220; D530043M21Rik; LHX; RAB2; RAB2A; RAB2B
UniProt ID: (Human) P61019, (Human) Q8WUD1, (Mouse) P53994, (Rat) P05712, (Mouse) P59279
Entrez Gene ID: (Human) 5862, (Human) 84932, (Mouse) 59021, (Rat) 65158, (Rat) 305853, (Mouse) 76338